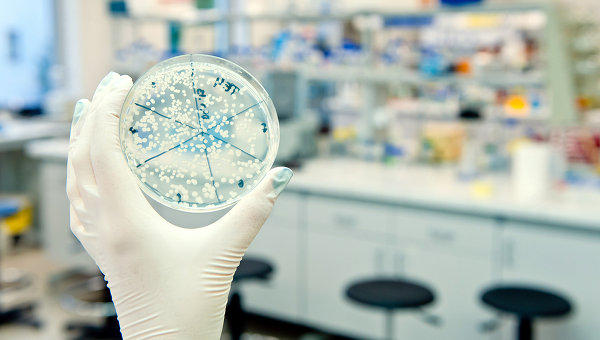

МОСКВА, 31 дек — РИА Новости. Эксперимент с бактериями, продолжающийся уже 25 лет, позволил ученым проследить, как генетические изменения, накапливаясь, приводят к возникновению нового вида , говорится в статье, опубликованной в журнале Proceedings of the National Academy of Sciences.
В 1988 году Ричард Ленски (Richard Lenski) из университета штата Мичиган в Ист-Лансинге (США) и его коллеги поместили 12 популяций кишечной палочки в пробирки с глюкозой и другими питательными веществами и стали наблюдать за их эволюцией. Один из самых громких результатов эксперимента ученые получили в 2003 году, примерно на 31,5-тысячном поколении бактерий.
Они обнаружили, что в одной из пробирок у бактерий развилась способность питаться цитратами (солями и эфирами лимонной кислоты), из-за чего они стали размножаться намного активнее остальных бактерий. Поскольку обычно кишечные палочки не могут питаться цитратами, этих бактерий ученые считают новым видом.
Теперь Джеффри Баррик (Jeffrey Barrick) из университета Техаса в Остине (США) и его коллеги разработали комбинацию техник анализа генома, чтобы выявить мутации, которые привели к появлению нового вида. Среди более 70 генетических изменений они обнаружили две критически важных мутации. Одна из них появилась первой и позволила бактериям усваивать цитраты. Однако это не привело к заметному росту популяции, поскольку они не могли питаться только цитратами, а зависели также и от глюкозы.
Эта мутация сохранялась среди бактерий 1,5 тысячи поколений (225 дней), пока у них в геноме не произошло еще одно изменение, которое позволило им сначала съедать всю глюкозу в растворе, а затем переходить на цитраты. Вместе эти генетические изменения привели к взрывному росту нового вида бактерий.
"Эффект этой (второй) мутации показывает, что совершенствование появившегося признака может быть так же важно для его успеха, как более ранние мутации или условия окружающей среды, которые изначально привели к его появлению", — заключают авторы статьи.


